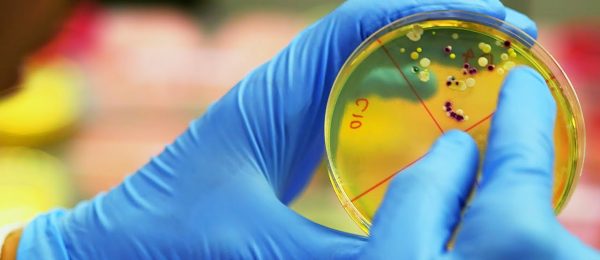

Seksiaddiktit paljastavat: ”Olen kuin vankina omassa kehossani”
Seksiaddiktio on tila, jossa normaali seksuaalinen kanssakäyminen lisääntyy huomattavasti pakkomielteisyyteen asti. Seksiriippuvuudesta kärsivä voi esimerkiksi kokea ahdistusta ja häpeää jatkuvasta seksin ajattelemisesta ja harrastamisesta. Nyt seksiaddiktit ovat anonyymisti kertoneet tilastaan.